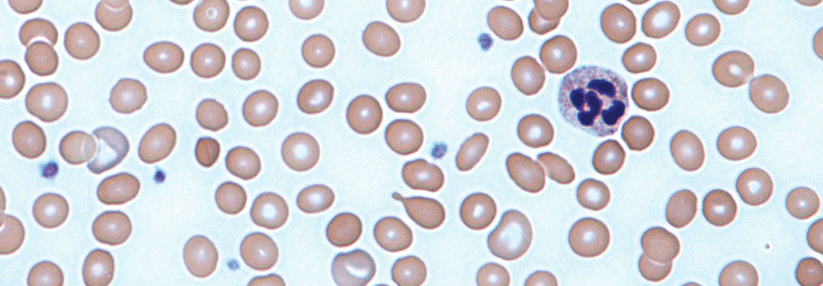

Aktive Darmentzündung erhöht das Risiko für Frühgeburt und Abort
 Der Kinderwunsch muss trotz CED nicht zerschlagen werden.
© fotolia/lassedesignen
Der Kinderwunsch muss trotz CED nicht zerschlagen werden.
© fotolia/lassedesignen
Die hohe Zahl kinderloser Patientinnen mit chronisch entzündlichen Darmerkrankungen (CED) spricht für Dr. Jens Walldorf von der Universitätsklinik für Innere Medizin I in Halle für eine „uninformierte Kinderlosigkeit“. Drei Fragen treiben die Frauen besonders um:
- Wird die CED auf den Nachwuchs vererbt?
- Gefährden die Medikamente Fertilität und das Ungeborene?
- Führen CED selbst zu mehr Fehlgeburten?
Insgesamt ist die Fertilität von Patientinnen mit CED zwar nicht beeinträchtigt, die biologische Uhr tickt bei ihnen aber schneller. Zudem sollte auch die chirurgische Therapie mit Blick auf den Kinderwunsch gestaltet werden. Ein Stoma z.B. stellt kein Risiko dar, erklärte Dr. Walldorf.…
Liebe Leserin, lieber Leser, aus rechtlichen Gründen ist der Beitrag, den Sie aufrufen möchten, nur für medizinische Fachkreise zugänglich. Wenn Sie diesen Fachkreisen angehören (Ärzte, Apotheker, Medizinstudenten, medizinisches Fachpersonal, Mitarbeiter der pharmazeutischen oder medizintechnischen Industrie, Fachjournalisten), loggen Sie sich bitte ein oder registrieren sich auf unserer Seite. Der Zugang ist kostenlos.
Benutzeranmeldung
Bitte geben Sie Ihren Benutzernamen und Ihr Passwort ein, um sich an der Website anzumelden.
Bei Fragen zur Anmeldung senden Sie bitte eine Mail an online@medical-tribune.de.